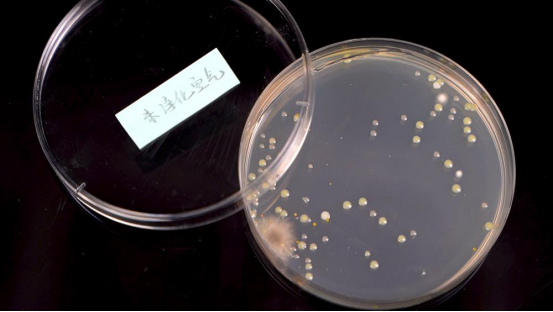

空气净化器买哪个牌子(万元级空气净化器强在哪里?)
空气净化器买哪个牌子(万元级空气净化器强在哪里?)
在疫情放开后的这段时间里,防疫物资涨了不知道有多少倍,大家前后的态度可谓是截然不同。在做好户外个人防护的同时,家里的空气质量也不容忽视,特别是冬天天冷不经常通风,各种细菌、微生物就开始活跃起来,更容易引起呼吸道感染。现在市面上的一些高端空气净化器都宣传有除菌消毒的能力,有的甚至还去申请了消字号备案,那么比起入门款,这些旗舰款的性能是不是真的有宣传的那么好呢?它们除了杀菌消毒,在其他方面还有些什么不同?本文将全部告诉你。
首先来看一下它们的基本参数,表格中的CADR就不用多说了,数字越高净化效率越高。下面两行的CCM可以理解成能够吸附的最大克数,一般情况下,数字越高能吸附的污染物就越多,相应的寿命就会长一些。P4、F4也就是标准下的最高等级,一般到这个价位,都会超出标准很多,但像IQAir超出近100倍的还真是不多见。

结构、噪音与净化效率
在排列结构上,我们常见的有塔式、半塔式、和双进风。这四款旗舰产品中IQAir是塔式,艾泊斯实际上也是塔式,上半部分可以根据不同场景更换不同的滤网,当然只要你有钞能力。科沃斯是半塔式,而舒乐氏是属于比较少见的四进风四出风设计。

结构的不同会带来两个方面的影响,一个是噪音,另一个是等风速下的净化效率。
先看噪音,有风机的产品这都是不可避免的,就看在不影响性能的情况下怎么去减少了。在相等风速下,双进风结构都要比塔式结构噪音更小,因为双进风的两侧就是大面积的入风口,然后从机身两侧或者顶部吹出,空气运动路径短,所以噪音比较小。

而塔式结构,一般是从底部比较狭窄的入风口吸入,往上经过一层又一层的滤网,风量必然衰减,为了保持出风量,就要加大进风量,噪音自然也就产生了。

各家的旗舰款在这一方面还是颇下了一番功夫的,比如塔式结构的艾泊斯就设计了32处密封降噪设计,像是降噪风机、密封条、EPS填充之类的。

四进四出的舒乐氏则是在降噪风机和滤网上下功夫,在最靠近风机的那层滤网有一层蜂窝式的结构,据说是有稳定气流降低噪音的作用。至于这些小设计行不行,咱们就来实际地测一测。

从我们的测试结果中不难看出,四进风的舒乐氏确实噪音要更小,而艾泊斯的32处降噪也确实有用,在相等3.6m/s的风速下,比科沃斯低了2分贝左右,但跟四进风结构比,还是有比较大的差距。IQAir简直离了大谱,开到最高档才和其他的中间档风速差不多,噪音也比较大,估计是塔式结构的同时隔音方面又没下太大功夫,有点影响日常体验了。




第二个就是我们前面提到的等风速下的净化效率,其实正经点的应该是等风量,但看了看风量仪,实在是承受不起啊。伪测一波风速,问题应该也不大。测试过程依旧是在这个30㎡左右的房间里依次点燃2g烟饼,记录净化20分钟后房间内的PM2.5。

从测试结果中我们可以看到,在将四款产品调到差不多的出风速度后,四进风的表现异常突出,领先另外三款一倍左右。虽然单次净化效率可能没有塔式高,但它胜在循环次数多,速度快,没有太复杂的滤料结构阻挡,所以即使在较小风速下,也能保持较大风量,同时噪音也更小,不得不说这就是双风机结构的优势啊。

甲醛测试
在习惯了活性炭滤芯不是柱状炭就是椰壳炭之后,从先看的这条视频里认识了另外一个品种——烧结炭。烧结炭有非常多的小孔,成本很高,但优点是有超强的吸附力,过滤精度可靠,也更环保。
这四款里舒乐氏用的就是烧结炭,这种类型的滤网不容易发酸,而且制作工艺更复杂,另外三款都是普通的柱状炭,吸附能力要略低于烧结炭。


不过只吸附是不够的,这四款都还用到了分解甲醛的技术。IQAir和艾泊斯用的是浸渍氧化铝,舒乐氏是光催化以及紫晶,科沃斯是高分子多氨,化学式我是看不懂了,意思就是可以把甲醛分解成二氧化碳和水。像先看那样测二氧化碳确实超过了我们的能力范围,不过常规测试还是可以来一波的。测试设备我们用到了理妍和霍尼韦尔甲醛检测仪,后者主要记录甲醛的变化过程。


从这张图中我们可以看到,IQAir在前6分钟都没有什么变化,在13分钟左右才降到了0.08的安全限值,前期是比较慢的。在同一时间达标的还有科沃斯,但他的表现就要好一些,至少数值全程都是在降低的;不过他们的甲醛CADR一个是140一个是310,按理应该会有差距,不懂不懂啊。剩下两款就要优秀多了,舒乐氏在8分钟左右就达到了0.08的标准,效率很高。艾泊斯稍慢一点,在9分钟左右达标。

虽然每一款用的时间不同,但相比起入门款,这些旗舰款对甲醛的净化效果都比较快,基本十几分钟就能净化到标准内,就看你是追求哪一种了。
细菌
疫情放开后去哪都离不开一个词,消毒。这四款旗舰空净都宣传自己有除菌除病毒的能力,uv灯、银离子是最常见的除菌手段了。舒乐氏更是加入了消字号认证,备案号网上都能查到,是真正的官方认证消毒机。但是要测试它就略微有些困难,病毒我们是搞不到了,别给自己号整没了。细菌这玩意儿可是到处都有,我们用最简单的琼脂培养皿来检验他们各自在除菌方面的能力。

在恒温培养48小时之后,净化和没净化的区别还是挺明显的。
舒乐氏整体数量、大小都是比较少的,然后科沃斯其次,最大菌落直径在5、6mm左右。艾泊斯和IQAir的最大菌落直径就在8mm以上了,不过艾泊斯菌落数是最少的,只有三个。

这也正好反映出各家所采用的除菌技术,艾泊斯和IQAir因为仅采用了HEPA滤网进行细菌的过滤,所以表现一般;

好一点的科沃斯则是多了一个UV灯消毒;

表现最好的舒乐氏除了一整条的UVC灯管,还有银离子滤网和等离子除菌,比较全面。

总的来说,只开启空净半小时就有这样的效果,确实已经很不错了,虽然不能百分百除掉所有的细菌,但是可以把细菌数量降到最低,所以用空气净化器为空气除菌确实是一个不错的选择。
其他
甲醛可以分解,细菌病毒可以消杀,其他杂质可就不行了,时间长了依旧需要更换滤网。不知道什么时候该换?那你可以打开他们各自的APP,查看耗材可用时间,寿命到了买个新滤网装上就OK了。

IQAir因为没有什么智能化,而且是全英文,所以啥时候还滤网全靠猜,感觉时间差不多了就换。然后有个小问题就是它没有像舒乐氏那种可水洗的尼龙滤网,直接就是一个初效滤网暴露在外面,使用时间长了就容易粘上各种毛发,家里有主子的可能会更惨一点,使用成本一下就增高了,毕竟换一个初效也挺贵的,艾泊斯也是这样,解决办法就是买个尼龙滤网,十块钱左右就能买一米,还是挺划算的。

此外,科沃斯滤网也有一个小问题。因为它把加湿模块放在了空气滤网的中间,活性炭长时间受潮会影响净化效率,所以给的建议就是不要加湿,或者少加湿,加湿结束拿到阳光底下晒一晒,会好很多。

而其他几款就是血统纯正的空气净化器,一丝多余的功能都没有。机身上集成了多个传感器,可以检测所在区域的VOC、PM2.5、温湿度,有的还配备了甲醛传感器,你问甲醛检测准吗,电化学传感器没有绝对准确,但至少你省了单独去买甲醛检测仪的钱,也可以有一个大致参考,何乐而不为呢。

总结
最后总结有句话得说一下,因为不乏有些杠精。确实不论净化什么都不如开窗通风来的更快,但你总有不想开窗或者不能开窗的时候吧,所以没有什么值不值,智不智商税,存在即合理,任何存在的事物都有其存在的原因,存在的一切事物都可以找到其存在的理由,黑格尔大佬名言送给在座各位。
在这个价位的旗舰款空气净化器各方面性能确实非常强,之前我们测过的某些入门款产品仅测试PM2.5这一项就要接近一个小时,花钱买舒适就是这个道理。但不好说是推荐你买哪一款,怕挨骂,像科沃斯,你是图他净化吗,不是。你是图他的自动化顺带了净化,家里来人会说“哟,高端,这玩意还会自己走”。同样IQAir也是如此,英文、纯进口这些产品不乏出现在一些受过高等教育的人身上,我遇到的一个人就是在他眼里进口=优质,但看我们的测试结果,好像并非如此,甚至不如我们的国产品牌。
这么看来艾泊斯和舒乐氏才是一心做产品,单一且专一,从各项测试数据来看,表现都是非常不错的,因为我们是自测结果,可能比不上更精确的实验室,但却是最贴合实际生活的。最后从产品结构来看,四进风无疑是更优的选择,在相等风速下,风量更大,循环速度更快,噪音更小,该怎么选你们都懂了吧。
OK,以上就是本文的全部内容了,希望能对你们挑选空气净化器有帮助,拜拜!
-
- 梁实秋简介(梁实秋简介人间食色)
-
2024-01-18 18:45:35
-
- 日元汇率走势(日元汇率又崩了,日本的未来危险了)
-
2024-01-18 18:43:30
-
- 南拳妈妈(专访南拳妈妈:谁的青春,被我们写成一首歌)
-
2024-01-18 18:41:25
-
- 国安部(国安局局长)
-
2024-01-18 18:39:20
-
- dnf战车(赛车dnf)
-
2024-01-18 18:37:15
-
- 王宝强的电影(王宝强的电影天注定)
-
2024-01-18 18:35:10
-
- 全世界gdp国家排名(全世界人均gdp国家排名)
-
2024-01-18 09:41:13
-
- 汉乐府是哪个朝代的(汉乐府是哪个朝代的诗人写的)
-
2024-01-18 09:39:07
-
- 丰田陆地巡洋舰价格(丰田陆巡多少钱)
-
2024-01-18 09:37:01
-
- 周稔丰个人简介(周稔丰个人简介是哪里人)
-
2024-01-18 09:34:54
-
- 被偏爱的都有恃无恐(男朋友说被偏爱的都有恃无恐)
-
2024-01-18 09:32:49
-
- 埃尔法和威尔法哪个档次高(埃尔法和威尔法的区别)
-
2024-01-18 09:30:42
-
- 为什么抗美援朝必须打(抗美援朝为何要打)
-
2024-01-18 09:28:36
-
- 羞耻意思是什么(羞耻的意思是什么意思)
-
2024-01-18 09:26:30
-
- 使用灭火器灭火的最佳位置是(使用灭火器灭火的最佳位置是上部中部根部)
-
2024-01-18 09:24:24
-
- 十大不建议购买的电动车(十大建议购买的电动车)
-
2024-01-18 09:22:19
-
- 唐宋四大家()
-
2024-01-18 03:48:22
-
- 方舟子事件是怎么回事(方舟出什么事了)
-
2024-01-18 03:46:17
-
- 好看的电视剧推荐 前十名(现在好看的电视剧推荐 前十名)
-
2024-01-18 03:44:12
-
- 名不正则言不顺(名不正则言不顺出自哪家思想)
-
2024-01-18 03:42:08



刘惜君到底和谁结婚了 她跟毛不易发生啥了
十大同性恋网站-同性恋网站有哪些-同性恋网站排行榜